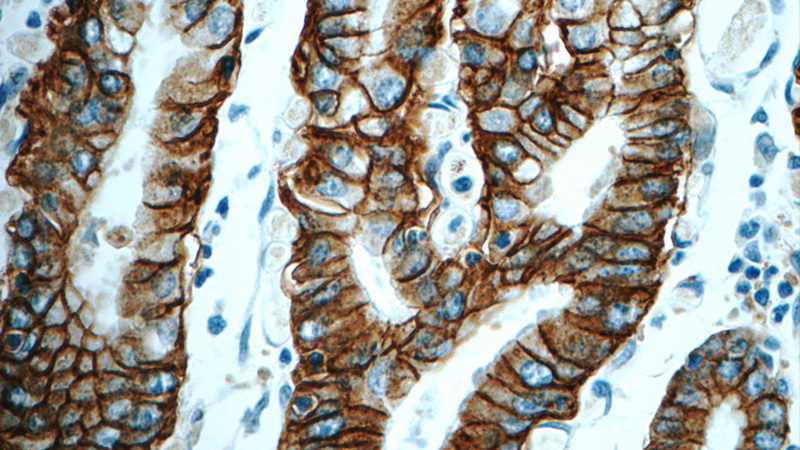
Immunohistochemistry of paraffin-embedded human stomach tissue slide using Catalog No:107159 (CLDN18 Antibody) at dilution of 1:600 (under 40x lens)
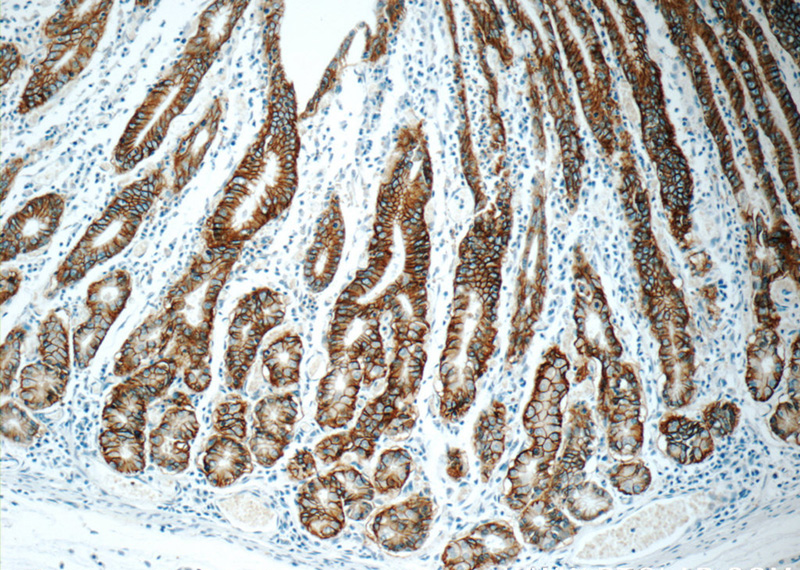
Immunohistochemistry of paraffin-embedded human stomach tissue slide using Catalog No:107159(CLDN18 Antibody) at dilution of 1:600 (under 10x lens)

-
Product Name
Claudin 18 antibody
- Documents
-
Description
Claudin 18 Mouse Monoclonal antibody. Positive IP detected in mouse stomach tissue. Positive IHC detected in human stomach tissue, human ovary tumor tissue, human pancreas cancer tissue. Observed molecular weight by Western-blot: 29 kDa
-
Tested applications
ELISA, IHC, IP
-
Species reactivity
Human, Mouse; other species not tested.
-
Alternative names
claudin 18 antibody; CLDN18 antibody; SFTA5 antibody; SFTPJ antibody
-
Isotype
Mouse IgG2a
-
Preparation
This antibody was obtained by immunization of Claudin 18 recombinant protein (Accession Number: NM_016369). Purification method: Protein A purified.
-
Clonality
Monoclonal
-
Formulation
PBS with 0.02% sodium azide and 50% glycerol pH 7.3.
-
Storage instructions
Store at -20℃. DO NOT ALIQUOT
-
Applications
Recommended Dilution:
IP: 1:200-1:1000
IHC: 1:200-1:1200
-
Validations

IP Result of anti-CLDN18 (IP:Catalog No:107159, 3ug; Detection:Catalog No:107159 1:300) with mouse stomach tissue lysate 4000ug.
Immunohistochemistry of paraffin-embedded human stomach tissue slide using Catalog No:107159 (CLDN18 Antibody) at dilution of 1:600 (under 40x lens)
Immunohistochemistry of paraffin-embedded human stomach tissue slide using Catalog No:107159(CLDN18 Antibody) at dilution of 1:600 (under 10x lens)
-
Background
Claudin 18 (CLDN18) belongs to the large claudin family of proteins, which are tetraspan transmembrane proteins of tight junctions (PMID: 11585919; 18036336). Claudins exhibit specific patterns of expression in different tissues (PMID: 15447685). CLDN18 is specifically expressed in the stomach and lung. CLDN18 has two alternatively spliced variants, CLDN18.1 and CLDN18.2. CLDN18.2 is a highly selective gastric lineage marker that determines the gastric phenotype in a neoplastic condition, whereas CLDN18.1 is lung specific (PMID: 11585919; 21832145). Altered CLDN18 expression has been reported in various human malignancies, including gastric cancer, lung adenocarcinoma, and pancreatic neoplasm (PMID: 17459057; 22076167; 21832145).
Related Products / Services
Please note: All products are "FOR RESEARCH USE ONLY AND ARE NOT INTENDED FOR DIAGNOSTIC OR THERAPEUTIC USE"
